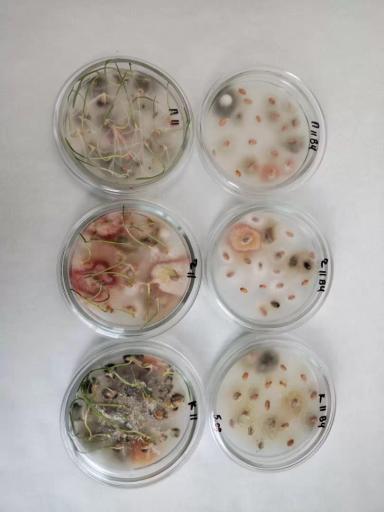

Посев семян с черным зародышем
- Все это условные патогены и паразитируют на ослабленных и погибших растениях.
- Использовать или нет семена озимой пшеницы для посева, у которых черный зародыш, решать только Вам. Нужно посмотреть на энергию прорастания и всхожесть таких семян.
- Если пораженных семян в образце много, это однозначно отразится на показателях энергии прорастания и всхожести, такие семена к посеву будут не допущены.
- Всхожесть семян озимой пшеницы ОС, ЭС и РС должна быть не менее - 92%, РСт не менее - 87%. По результатам фитоэкспертизы кондиционными признаются семена, если партия поражена комплексом патогенов не более чем на 10-15 %.
- Если энергия прорастания низкая - например менее 50%, всходы будут изреженные (и без разницы, увеличиваете вы норму высева или наоборот, понижаете), потому что это зерно физиологически недоразвито. Ну посеете вы это зерно, ну взойдёт оно у вас проплешинами... С каждым годом использования для посева, ситуация с таким зерном будет только хуже - не стоит даже это проверять!
- Агрономы говорят, что все таки, если выбора нет и других семян нет, то протравливают и высевают такие семена. От альтернарии поможет - дифеноконазол. От гельминтоспориоза - любой качественный протравитель.
- В поле Alternaria spp. вызывает чернь колоса. Bipolaris sorokiniana Sacc. вызывает корневые гнили и темно-бурую пятнистость листьев.
Заражение ослабленных растений происходит во время цветения. Для развития оптимальна температура +20-28 градусов, необходимо наличие влаги. Потери урожая могут достигать 10-20%.
Полученное зерно от таких семян допускается на фуражные цели, т.к. не токсично.
Мука, выработанная из партий с высоким содержанием зерна, пораженного черным зародышем, менее ценна для производства хлебобулочных и макаронных изделий. Мука получается с "черными точками" (вкраплениями) - это сильно понижает ее цену.
Также наличие черного зародыша в зерне твердых сортов пшениц ограничивает экспорт этой маржинальной культуры.
Хранить лучше всего не больше года, а партии для помола необходимо изучать на % пораженности грибами.
💥Оставляйте комментарии, ставьте лайки, ПОДПИСЫВАЙТЕСЬ на Агронома Direct.Farm, чтобы не пропустить новые посты из сервиса Помощи агронома.

6 комментариев
Такое зерно по факту является зараженным грибом Alternaria spp., Helminthosporium spp. (поражают само зерно и его органы вегетации).
НО, такое зерно допускается на фуражные цели, т.к. не токсично. Мука будет с "черными точками" (вкраплениями) - это сильно понижает ее цену при изготовлении продуктов питания. Класс семян как правило понижается вместе с ценой при продажи. Хранить лучше всего не больше года, а партии для помола необходимо изучать на % пораженности грибами.⚠️☝️